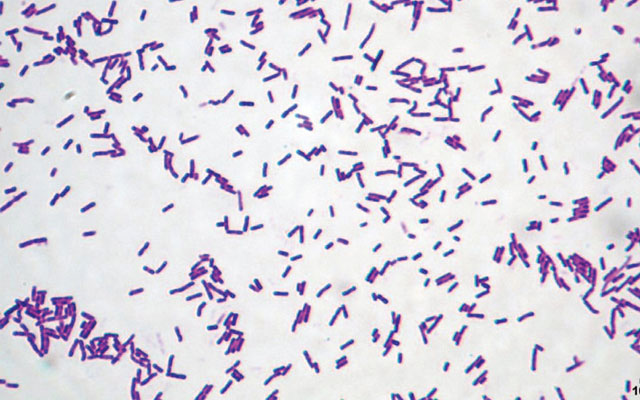

Quản lý hệ vi khuẩn trong nuôi tôm
Đánh giá bài viếtVi khuẩn có mặt khắp mọi nơi trong hệ sinh thái ao nuôi và đóng một vai trò quan trọng trong việc duy trì sức khỏe tôm và năng suất nuôi. Quản lý hệ vi khuẩn góp phần giảm thiểu các nguy hại và tạo thành công cho vụ nuôi.
Hệ vi khuẩn
Từ trong môi trường nước ao đến đường ruột của tôm, vi khuẩn có mặt ở khắp mọi nơi. Ao là một hệ sinh thái phức tạp, liên quan đến các vật chất hữu cơ và chất dinh dưỡng tái sử dụng hoặc loại bỏ, đặc biệt là nitơ. Cùng với thực vật phù du, vi khuẩn đang thống trị hệ thống sinh thái này. Các cộng đồng vi khuẩn trong ao là một phần của chuỗi thức ăn, góp phần vào quá trình sinh học và đóng một vai trò quan trọng trong kiểm soát vệ sinh ao. Tuy nhiên, một sự thay đổi trong hệ sinh thái cân bằng này có thể dẫn đến sự phát triển quá mức của các vi khuẩn không mong muốn, bao gồm cả các mầm bệnh tiềm tàng hoặc ảnh hưởng đến chu kỳ nitơ và việc loại bỏ các chất hữu cơ. Từ đó, tác động đến sức khỏe tôm và hiệu suất ao nuôi.
Đối với hệ vi khuẩn trong đường ruột tôm, cho đến nay vẫn còn rất ít nghiên cứu về vai trò của chúng trong tôm. Nhưng những phát hiện cho đến nay trong việc bổ sung các vi sinh vào đường ruột của tôm đã hỗ trợ một vai trò cơ bản trung giản trong việc nâng cao sức khỏe tôm. Đặc biệt là các nghiên cứu khác nhau cho thấy chế phẩm sinh học trong thức ăn có khả năng điều chỉnh hệ vi sinh vật đường ruột tôm, tác động tích cực về việc giảm stress, chống ôxy hóa và cải thiện sự sống cho tôm.
Cấu trúc vi khuẩn Bacillus licheniformis
Mối liên hệ giữa vi khuẩn trong môi trường và vi khuẩn đường ruột luôn tác động qua lại với nhau do hoạt động thông thường của vi khuẩn qua các hoạt động tiêu hóa, thức ăn đi vào ruột, nước di chuyển qua đường miệng, do vi khuẩn cư trú tạm thời và nhiều nhân tố khác như hình dáng, cấu tạo bên ngoài của vật nuôi, cấu trúc hệ tiêu hóa, chế độ ăn, điều kiện sống của vật chủ và vụ nuôi (theo Harris, 1993).
Quản lý hệ vi khuẩn trong ao
Các khái niệm xử lý sinh học đã được áp dụng rộng rãi trong nuôi trồng thủy sản trong nhiều thập kỷ qua với mục đích tạo thuận lợi cho việc quản lý các hợp chất hữu cơ và nitơ tích tụ trong hệ thống nuôi (chất lượng nước và đáy ao). Tiêu chí lựa chọn một vi khuẩn để sử dụng trong ao nuôi gồm: có khả năng cạnh tranh; thích nghi với các môi trường khác nhau (độ mặn, ôxy hòa tan…); an toàn (không có các gen kháng kháng sinh và độc tố); hoạt động đối kháng khuẩn; có khả năng loại bỏ nitơ và các chất hữu cơ. Trong ao nuôi tôm, thường sử dụng các nhóm vi sinh vật có tính đối kháng hoặc cạnh tranh thức ăn với vi sinh vật gây bệnh như vi khuẩn Bacillus sp, Bacillus licheniformis… Nhóm cải thiện chất lượng môi trường như vi khuẩn Nitrosomonas, Nitrobacter, Actinomyces, Bacillus, Rhodobacter sp, Rhodospirillum, Rhodopseudomonas viridis…
Việc sử dụng các vi khuẩn có lợi để quản lý hệ vi sinh trong ao nuôi có tác dụng: làm sạch nền đáy ao, phân hủy chất hữu cơ hấp thu xác tảo, làm giảm sự gia tăng lớp bùn ao; ức chế sự hoạt động và phát triển của các vi khuẩn có hại; chuyển hóa các khí độc gây hại cho tôm như NH3, NO2, H2S…; giúp ổn định tảo và màu nước ao nuôi; một số chủng vi khuẩn khi sử dụng sẽ làm tăng hàm lượng ôxy, ổn định pH và các chỉ số môi trường trong ao nuôi. Hoặc sử dụng hệ thống nuôi Biofloc cũng có khả năng quản lý thành công hệ vi sinh trong ao.
Quản lý hệ vi khuẩn đường ruột
Theo nghiên cứu của Chaiyapechara và cộng sự, năm 2011 cho thấy quần thể vi khuẩn đường ruột tôm sú gồm: Giống vi khuẩn chiếm ưu thế trong ruột tôm bao gồm Vibrio, Photobacterium, Aeromonas, Propionigenium (ngành Fusobacteria). Các giống khác như Actinomyces, Anaerobaculum, Halospirulina, Pseudomonas, Mycoplasma và Shewanella; vi khuẩn kỵ khí bắt buộc như Propionigenium và Fusibacter cũng đã được tìm thấy. Theo nghiên cứu của Johnson và cộng sự, năm 2008, trên tôm thẻ chân trắng cho biết ruột trước của tôm nuôi trong bể tuần hoàn bao gồm các nhóm vi khuẩn Mycobacterium, Propionibacterium, và Desulfocapsa chiếm ưu thế; ruột sau có nhóm Vibrio chiếm ưu thế.
Đường ruột gần như là bộ phận quan trọng nhất đối với tôm và mục tiêu cho các bệnh nguy hiểm. Bởi, cơ thể tôm có cấu tạo rất đơn giản và rất dễ mẫn cảm với mầm bệnh. Hiện, các bệnh xuất hiện phần lớn đều xuất phát từ đường ruột như phân trắng, hội chứng tôm chết sớm (EMS)… Vào thời điểm việc sử dụng kháng sinh ngày càng hạn chế, thì việc quản lý hệ vi khuẩn đường ruột một cách tích cực thông qua việc bổ sung các chế phẩm vào thức ăn là một cách tiếp cận đầy hứa hẹn. Theo nghiên cứu của các nhà khoa học, việc bổ sung các vi khuẩn có lợi vào đường ruột giúp tôm tiêu hóa tốt thức ăn, hấp thụ dinh dưỡng, hạn chế độc tố, ức chế vi khuẩn có hại, bảo vệ sức khỏe tôm nuôi và giúp phòng bệnh trên tôm như phân trắng… nâng cao tỷ lệ sống. Nhóm vi khuẩn được sử dụng cho việc cải thiện đường ruột tôm bằng cách trộn vào thức ăn thường là các vi khuẩn Lactobacillus, Bacillus sp, Saccharomyces… Chế phẩm sinh học được khuyến cáo sử dụng trong mọi giai đoạn của nghề nuôi tôm, bắt đầu từ khi con giống đến lúc nuôi thương phẩm. Bởi, các nghiên cứu đã chỉ ra rằng những con giống được sản xuất dựa trên việc sử dụng thường xuyên chế phẩm sinh học có tỷ lệ sống và sức tăng trưởng cao hơn những con giống bị ảnh hưởng bởi việc sử dụng kháng sinh hay hóa chất. Đồng thời, các vi khuẩn có lợi còn tiết ra các enzym có khả năng phân tách các đa chất thành các đơn chất giúp tôm dễ hấp thụ dinh dưỡng, chống rối loạn đường tiêu hóa của tôm.
>> Nuôi tôm hiện nay đang gặp nhiều thách thức bởi khi áp lực từ chất lượng môi trường nuôi và nhu cầu lương thực ngày càng tăng. Việc sử dụng các hệ vi khuẩn bổ sung trong thức ăn và môi trường nuôi thông qua các biện pháp quản lý và kiểm soát hệ vi khuẩn dưới đáy ao, trong nước sẽ giúp tối ưu hóa hiệu suất tôm, và nuôi tôm một cách toàn diện, bền vững. |
Các tin mới nhất
Các tin cũ cùng mục
- Thả giống nuôi tôm nước lợ(18/08/2021)
- Các vấn đề thường gặp và kỹ thuật để nuôi tôm thành công(18/08/2021)
- Nuôi thức ăn cho ấu trùng tôm(18/08/2021)
- Hạn chế và tiêu diệt sứa nước trong ao nuôi tôm(18/08/2021)
- Xử lý nước nuôi tôm theo đúng quy trình để đạt hiệu quả cao(18/08/2021)
- Hướng dẫn cách nuôi và kỹ thuật nuôi con tôm càng xanh cơ bản(18/08/2021)
- Quy trình kỹ thuật sản xuất giống tôm thẻ chân trắng khỏe mạnh(18/08/2021)
- Hướng dẫn quy trình nuôi tôm thẻ chân trắng để đạt hiệu quả cao(18/08/2021)






























Bình luận bài viết